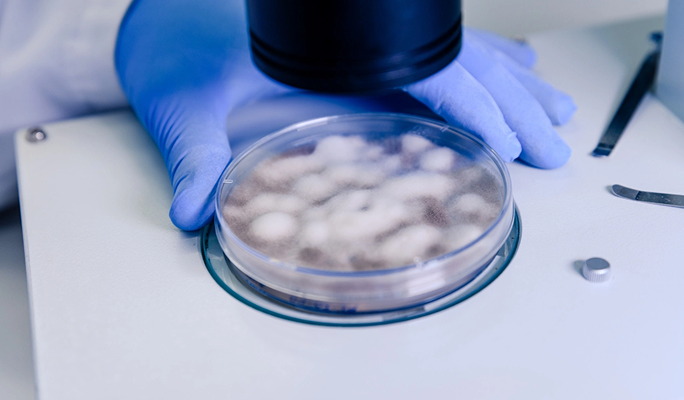
Embryo Oocyte and Sperm Cryopreservation

Fertility Treatment Abroad, Affordable IVF With High Success Rates
Fertility treatment abroad offers couples and individuals access to IVF, ICSI, egg donation, surrogacy, IUI, and fertility preservation programs at world-class reproductive medicine centers. Specialists use advanced embryology techniques and personalized hormonal protocols to maximize the chance of a successful pregnancy. Fertility treatment costs can be a significant barrier for many families. An IVF cycle that costs $15,000 to $25,000 at home may be available for $3,000 to $6,000 abroad at equally equipped clinics with internationally trained reproductive endocrinologists and high success rates. Leading international fertility centers offer shorter waiting times, extensive donor databases, and multilingual coordinators who support patients throughout every stage of their journey. Patients report receiving more personalized, attentive care than they experienced in their home country. The clinic's laboratory quality and the reproductive specialist's experience are the most important factors. Always verify IVF success rates, laboratory accreditation, and embryologist credentials. Your individual fertility diagnosis, response to stimulation, and embryo quality all play a significant role in outcomes.

Fertility Treatment Abroad, Affordable IVF With High Success Rates
Fertility treatment abroad offers couples and individuals access to IVF, ICSI, egg donation, surrogacy, IUI, and fertility preservation programs at world-class reproductive medicine centers. Specialists use advanced embryology techniques and personalized hormonal protocols to maximize the chance of a successful pregnancy. Fertility treatment costs can be a significant barrier for many families. An IVF cycle that costs $15,000 to $25,000 at home may be available for $3,000 to $6,000 abroad at equally equipped clinics with internationally trained reproductive endocrinologists and high success rates. Leading international fertility centers offer shorter waiting times, extensive donor databases, and multilingual coordinators who support patients throughout every stage of their journey. Patients report receiving more personalized, attentive care than they experienced in their home country. The clinic's laboratory quality and the reproductive specialist's experience are the most important factors. Always verify IVF success rates, laboratory accreditation, and embryologist credentials. Your individual fertility diagnosis, response to stimulation, and embryo quality all play a significant role in outcomes.
Overview
Fertility treatment abroad offers couples and individuals access to IVF, ICSI, egg donation, surrogacy, IUI, and fertility preservation programs at world-class reproductive medicine centers. Specialists use advanced embryology techniques and personalized hormonal protocols to maximize the chance of a successful pregnancy.
Fertility treatment costs can be a significant barrier for many families. An IVF cycle that costs $15,000 to $25,000 at home may be available for $3,000 to $6,000 abroad at equally equipped clinics with internationally trained reproductive endocrinologists and high success rates.
Leading international fertility centers offer shorter waiting times, extensive donor databases, and multilingual coordinators who support patients throughout every stage of their journey. Patients report receiving more personalized, attentive care than they experienced in their home country.
The clinic's laboratory quality and the reproductive specialist's experience are the most important factors. Always verify IVF success rates, laboratory accreditation, and embryologist credentials. Your individual fertility diagnosis, response to stimulation, and embryo quality all play a significant role in outcomes.
Procedure Variety
Options include IVF, ICSI, IUI, egg donation, surrogacy, and fertility preservation.
Treatment Goals
Achieve successful pregnancy through personalized, evidence-based reproductive protocols.
Popular Treatments
IVF with PGT, donor egg IVF, ICSI, frozen embryo transfer, and fertility preservation.
Safety Standards
Choose accredited clinics with certified embryologists and transparent IVF success rate data.

Clomid treatments
Through the application of Clomid treatments, healthcare providers are able to address complex medical conditions with precision, utilizing the latest advancements in technology and evidence-based practices.

In Vitro Fertilization (IVF)
"IVF treatment abroad provides an effective fertility solution for individuals and couples who are experiencing difficulties conceiving naturally. In vitro fertilization (IVF) is a medically advanced procedure where eggs are retrieved from the ovaries and fertilized with sperm in a specialized laboratory. Once fertilization occurs, the resulting embryo is carefully monitored and then transferred into the uterus to support implantation and pregnancy. Through CureMeAbroad, patients gain access to internationally accredited fertility clinics known for their advanced reproductive technologies, highly experienced fertility specialists, and patient-centered care. Each treatment plan is tailored to the individual’s medical history, fertility condition, and family goals to maximize the chances of success. Patients also benefit from comprehensive support throughout the process, including medical guidance, treatment coordination, and travel assistance. Seeking IVF treatment abroad can offer access to world-class fertility expertise, modern facilities, and personalized care designed to support patients on their journey toward parenthood."

IUI Treatment
A commonly recommended fertility procedure, intrauterine insemination (IUI) helps improve the chances of pregnancy by placing specially prepared sperm directly into the uterus during ovulation. This minimally invasive treatment is often suggested for couples experiencing mild infertility, unexplained infertility, or certain sperm-related issues. By placing the sperm closer to the egg, the procedure increases the likelihood of fertilization while remaining relatively simple and less intensive than other assisted reproductive techniques. Through CureMeAbroad, patients can connect with internationally accredited fertility clinics that offer advanced reproductive technologies and experienced fertility specialists. Each patient receives a personalized treatment plan based on their medical history, fertility condition, and reproductive goals. Clinics provide thorough fertility evaluations, professional guidance, and continuous support throughout the treatment process. Seeking fertility care abroad allows patients to access modern medical facilities, expert reproductive care, and comprehensive support designed to help individuals and couples move closer to achieving a successful pregnancy.

Ovulation Induction (OI)
Ovulation Induction (OI) represents an innovative procedure aimed at enhancing diagnostic accuracy, delivering targeted therapy, or facilitating surgical precision depending on the patient's unique needs.

ICSI Treatment
The ICSI treatment overseas is a sophisticated method for Assisted Reproductive Technology in helping men and women suffering from male infertility achieve conception. The process of ICSI treatment involves the injection of one spermatozoon into an oocyte under high magnification and sterile conditions. ICSI treatment is typically offered to those who are experiencing low sperm count, poor motility or poor sperm quality. After successful insemination, the developing embryo undergoes close monitoring prior to transfer to the woman's uterus for a successful pregnancy. CureMeAbroad facilitates patients' access to world-class fertility clinics which have modern embryology laboratories and the latest reproductive technology available. Each individual receives a personalized plan based on their specific fertility needs by experienced fertility experts. CureMeAbroad provides patients with all the help they need during their entire fertility experience including pre-treatment consultations through to post-treatment support. By receiving ICSI treatment overseas, patients will be able to take advantage of the best possible care from highly trained professionals, state-of-the-art fertility facilities and the personal support necessary to assist both men and women to make their dreams of parenthood a reality.

Cytoplasmic IVF
Cytoplasmic IVF, or cytoplasmic transfer, is an advanced reproductive technique that involves transferring a small amount of cytoplasm from a healthy donor egg into a patient's own egg, improving mitochondrial function and enhancing the embryo's developmental potential. It is particularly beneficial for patients with repeated IVF failures or poor egg quality. Travelling abroad for cytoplasmic IVF gives you access to highly specialised fertility clinics and reproductive scientists at the forefront of assisted reproduction, at considerably lower costs than at home. On CureMeAbroad, compare verified providers, explore leading destinations, and review transparent pricing honestly. No commissions, no pressure, just confident decision-making.

ICSI with IMSI
"ICSI with IMSI abroad is a highly advanced fertility treatment designed to improve fertilization outcomes by enhancing the sperm selection process. Intracytoplasmic Sperm Injection (ICSI) involves injecting a single sperm directly into an egg, while Intracytoplasmic Morphologically Selected Sperm Injection (IMSI) uses powerful high-magnification microscopy to examine sperm in greater detail before selection. This advanced evaluation helps embryologists choose the healthiest sperm, which may increase the chances of successful fertilization and better embryo development. Through CureMeAbroad, patients can access internationally accredited fertility clinics equipped with state-of-the-art embryology laboratories and advanced reproductive technologies. Skilled fertility specialists and experienced embryologists carefully assess each patient’s condition and design personalized treatment plans tailored to their fertility needs. Patients also receive continuous medical guidance and coordinated support throughout the treatment journey. Choosing ICSI with IMSI abroad allows patients to benefit from cutting-edge fertility techniques, expert medical care, and specialized reproductive support aimed at improving the chances of a successful pregnancy."

Tandem IVF Cycle
A tandem IVF cycle combines a patient's own eggs with donor eggs in a single treatment cycle, maximising the chances of a successful pregnancy while still giving patients the opportunity to conceive with their own genetic material. It is particularly suited to women with diminished ovarian reserve or advanced maternal age who wish to explore both options simultaneously. Travelling abroad for a tandem IVF cycle connects you with leading fertility specialists and state-of-the-art reproductive clinics at considerably lower costs than at home. On CureMeAbroad, compare verified providers, explore top destinations, and review transparent pricing. No commissions, no pressure, just clarity.

IVF with ICSI
"IVF with ICSI abroad combines two advanced assisted reproductive technologies to enhance fertilization and improve the chances of a successful pregnancy. This treatment involves retrieving eggs from the ovaries and fertilizing them in a specialized laboratory through in vitro fertilization (IVF). In cases where male infertility factors are present, Intracytoplasmic Sperm Injection (ICSI) is used to inject a single healthy sperm directly into the egg, helping ensure successful fertilization and healthy embryo development. The resulting embryo is then carefully monitored before being transferred into the uterus. Through CureMeAbroad, patients can connect with internationally accredited fertility clinics equipped with modern embryology laboratories and advanced reproductive technologies. Experienced fertility specialists evaluate each case and create personalized treatment plans tailored to the patient’s fertility needs. Patients also receive comprehensive support throughout the treatment journey, including medical coordination and guidance. Choosing IVF with ICSI abroad provides access to expert care, advanced fertility solutions, and dedicated support to help patients achieve their goal of parenthood."

IVF with Embryo Donation and Gender Selection
For individuals or couples facing complex fertility challenges, embryo donation combined with gender selection can provide an alternative path to achieving pregnancy. In this treatment approach, donated embryos created through in vitro fertilization (IVF) are transferred into the uterus of the intended mother. In countries where regulations allow, advanced genetic screening techniques may be used to identify the gender of embryos before implantation, supporting specific family planning preferences. Through CureMeAbroad, patients can connect with internationally recognized fertility clinics that offer well-regulated embryo donation programs and advanced reproductive technologies. Experienced fertility specialists carefully evaluate each case and develop personalized treatment plans based on the patient’s medical history and reproductive goals. Clinics also follow strict medical and ethical standards to ensure safe and responsible treatment practices. With access to modern fertility laboratories and expert guidance, patients receive comprehensive support throughout the journey toward achieving a healthy and successful pregnancy.

IVF with Gender Selection
Advanced reproductive technologies now allow intended parents to choose the gender of their baby during the IVF process through specialized genetic screening techniques. This approach is typically performed using preimplantation genetic testing (PGT), where embryos created through in vitro fertilization are analyzed before being transferred to the uterus. The screening process helps identify the gender of the embryos while also evaluating their chromosomal health, supporting safer and more informed embryo selection. This treatment option is available in select countries where gender selection is legally permitted and carefully regulated. Through CureMeAbroad, patients can connect with internationally recognized fertility clinics that offer advanced embryology laboratories, modern genetic testing technologies, and experienced fertility specialists. Each patient receives a personalized treatment plan based on their medical needs and family planning goals. With expert medical care and coordinated support throughout the journey, patients can access reliable fertility solutions abroad while working toward achieving a healthy and successful preg

Microdissection TESE (Testicular Sperm Extraction)
Choosing Microdissection TESE from abroad provides access to experienced fertility specialists, advanced reproductive labs, and cost-effective treatment options. Patients benefit from high success rates, personalized care plans, and comprehensive support through CureMeAbroad for a smooth and stress-free journey. Microdissection TESE (Testicular Sperm Extraction) is a specialized surgical procedure used to retrieve sperm directly from the testicular tissue in men with non-obstructive azoospermia. Using a high-powered microscope, doctors can identify and extract viable sperm with greater precision. The retrieved sperm can then be used in assisted reproductive techniques such as IVF or ICSI, offering hope to couples facing male infertility.

Natural Cycle and ICSI
"Natural Cycle ICSI abroad is a fertility treatment approach that works in harmony with a woman’s natural menstrual cycle rather than relying on high doses of fertility medications. In this procedure, a single egg that develops naturally during the cycle is carefully retrieved and fertilized using Intracytoplasmic Sperm Injection (ICSI), where one healthy sperm is injected directly into the egg in a specialized laboratory. The resulting embryo is then monitored and transferred to the uterus to support pregnancy. Through CureMeAbroad, patients can access internationally recognized fertility clinics that specialize in advanced reproductive technologies and patient-focused care. Experienced fertility specialists evaluate each patient’s condition and develop personalized treatment plans designed to match their unique fertility needs. Natural Cycle ICSI may be recommended for patients who prefer a more natural approach or wish to minimize medication use. With expert guidance and modern fertility facilities, patients receive comprehensive support throughout their treatment journey toward parenthood."

PESA - Percutaneous Epididymal Sperm Aspiration
PESA - Percutaneous Epididymal Sperm Aspiration is a critical component of modern medicine, offering patients access to minimally invasive, highly effective treatments that can significantly improve outcomes across various health domains.

FET (Frozen Embryo Transfer)
Frozen Embryo Transfer Cycle represents an innovative procedure aimed at enhancing diagnostic accuracy, delivering targeted therapy, or facilitating surgical precision depending on the patient's unique needs.

Preimplantation Genetic Diagnosis (PGD)
Preimplantation genetic diagnosis, or PGD, is an advanced genetic testing technique performed on embryos during an IVF cycle to screen for specific inherited genetic conditions, chromosomal abnormalities, or single gene disorders before implantation. It gives prospective parents the opportunity to select the healthiest embryos, significantly reducing the risk of passing on hereditary conditions and improving the chances of a successful pregnancy. Travelling abroad for PGD connects you with highly specialised fertility geneticists and state-of-the-art reproductive laboratories at considerably lower costs than at home. On CureMeAbroad, compare verified providers, explore top destinations, and review transparent pricing honestly. No commissions, no pressure, just clarity.

Surrogacy
Surrogacy is an option for people and couples wanting to have a child but cannot become pregnant due to a health condition or another circumstance. A surrogate will carry and deliver a child for the intended parent(s), and the entire process is monitored closely by experienced fertility doctors and medical professionals. Advanced reproductive technologies (ART) such as IVF, are commonly used to produce embryos that will be placed into the surrogate's uterus. Through CureMeAbroad, patients can find and work with trustworthy fertility centers and structured surrogacy programs in top international medical travel locations. The fertility centers and surrogacy programs offer programs and services that focus on ethical practices, and comply with all applicable laws. Additionally, patients are able to work with one person throughout the program, and will receive personalized guidance and support during all stages of their treatment, from first consultation and treatment planning, through to pregnancy and delivery.

IVF with Egg Donation and Gender Selection
IVF with egg donation and gender selection abroad combines advanced assisted reproduction with genetic screening technology to support specific family planning goals. This treatment is often recommended for patients who are unable to conceive using their own eggs while also wishing to determine the gender of the embryo before implantation. The process involves fertilizing carefully screened donor eggs with sperm in a specialized laboratory using IVF techniques. After fertilization, embryos may undergo genetic testing to identify their gender and assess overall chromosomal health before the selected embryo is transferred into the uterus. Through CureMeAbroad, patients can access internationally accredited fertility clinics equipped with advanced embryology laboratories and modern genetic screening technologies. Experienced fertility specialists create personalized treatment plans based on each patient’s medical needs and reproductive goals. By choosing IVF with egg donation and gender selection abroad, patients benefit from expert medical care, advanced fertility techniques, and dedicated support designed to improve the chances of a healthy and successful pregnancy.

IVF(In Vitro fertilization) with Egg Donation
"IVF with egg donation abroad is an effective fertility solution for women who are unable to conceive using their own eggs due to age, medical conditions, or diminished ovarian reserve. In this procedure, healthy eggs from a carefully screened donor are fertilized with sperm in a specialized laboratory using advanced in vitro fertilization (IVF) techniques. Once fertilization occurs, the resulting embryo is closely monitored before being transferred into the intended mother’s uterus to support a successful pregnancy. Through CureMeAbroad, patients can connect with internationally accredited fertility clinics that offer well-regulated egg donor programs, modern embryology laboratories, and experienced fertility specialists. Donor selection processes are carefully managed to ensure medical safety and compatibility while maintaining high ethical and medical standards. Each patient receives a personalized treatment plan along with continuous guidance throughout the journey. Seeking IVF with egg donation abroad allows patients to benefit from advanced reproductive technologies, expert fertility care, and supportive programs designed to help achieve successful parenthood."

IVF with Sperm Donation and Gender Selection
For individuals or couples experiencing male infertility or concerns about inherited genetic conditions, using donor sperm combined with gender selection can offer an effective fertility solution. In this treatment process, eggs are fertilized with carefully screened donor sperm in a specialized laboratory through in vitro fertilization (IVF). The resulting embryos may undergo advanced genetic screening to identify their gender and evaluate chromosomal health before the selected embryo is transferred into the uterus. This treatment option is available in countries where gender selection is legally permitted and performed under strict medical guidelines. Through CureMeAbroad, patients can connect with internationally accredited fertility clinics that offer regulated sperm donor programs, advanced reproductive technologies, and experienced fertility specialists. Each patient receives a personalized treatment plan tailored to their medical condition and family planning goals. With access to modern fertility laboratories and expert medical guidance, patients receive comprehensive support throughout their journey toward achieving a successful pregnancy.

IVF with Sperm Donation
IVF with sperm donation offers a safe, effective path to parenthood for single women, same-sex female couples, and heterosexual couples affected by male factor infertility. Using carefully screened donor sperm from accredited sperm banks, fertility specialists abroad deliver the same high standards of care and success rates as clinics at home, often at a significantly lower overall cost. Travelling abroad for this treatment also provides access to a wider donor pool and more flexible legal frameworks in many destinations. On CureMeAbroad, compare verified providers, explore top medical tourism destinations, and review transparent pricing. No commissions, no sales pressure, just honest guidance.

Sperm Freezing
Sperm freezing, or sperm cryopreservation, allows men to preserve healthy sperm samples for future use in assisted reproduction treatments such as IVF or IUI. It is an important option for men facing medical treatments such as chemotherapy, those planning a vasectomy, or anyone wishing to safeguard their fertility before age-related decline. Travelling abroad for sperm freezing gives you access to advanced andrology laboratories and experienced fertility specialists at considerably lower costs than at home. On CureMeAbroad, compare verified providers, explore leading medical tourism destinations, and review transparent pricing with complete honesty. No commissions, no pressure, just the clarity to plan ahead confidently.

Embryo Freezing
Embryo freezing, or embryo cryopreservation, is a process that preserves fertilised embryos at sub-zero temperatures for future use in IVF treatment. It offers patients greater flexibility, reduces the physical and financial burden of repeated stimulation cycles, and provides a valuable safety net for those undergoing medical treatments that may affect future fertility. Travelling abroad for embryo freezing gives you access to state-of-the-art reproductive laboratories and experienced embryologists at considerably lower costs than at home. On CureMeAbroad, compare verified fertility clinics, explore top medical tourism destinations, and review transparent pricing honestly. No commissions, no sales pressure, just confident and informed decision-making.

Uterine Removal
The Uterine Removal is a cutting-edge medical intervention designed to diagnose, treat, or manage specific health conditions with a focus on improving patient longevity and quality of life.

Egg donation with Sperm Donation
For individuals or couples facing complex fertility challenges, using donor eggs and donor sperm can provide an effective path toward achieving pregnancy. This treatment approach is often recommended when both partners experience infertility issues or when there are concerns about passing genetic conditions to the child. During the process, eggs and sperm from carefully screened donors are used to create embryos in a specialized laboratory through advanced in vitro fertilization (IVF) techniques. The resulting embryo is then closely monitored before being transferred into the uterus to support a healthy pregnancy. Through CureMeAbroad, patients can connect with internationally accredited fertility clinics that offer regulated donor programs, modern reproductive technologies, and experienced fertility specialists. Donors undergo strict medical and genetic screening to ensure safety and compatibility. Each patient receives a personalized treatment plan along with dedicated guidance throughout the entire fertility journey, helping them move confidently toward building their family.

TESA (Testicular Sperm Aspiration)
Choosing TESA treatment from abroad allows patients to access skilled fertility specialists, modern reproductive technologies, and affordable care. With shorter waiting times and personalized treatment plans, CureMeAbroad ensures a seamless and supportive experience throughout the fertility journey. TESA (Testicular Sperm Aspiration) is a minimally invasive procedure used to extract sperm directly from the testicles using a fine needle. It is commonly recommended for men with obstructive azoospermia or other sperm retrieval challenges. The collected sperm can be used for assisted reproductive procedures such as IVF or ICSI, helping couples achieve successful pregnancy outcomes.

Egg and Ovarian Cortex Freezing
Preserving fertility has become an important option for women who wish to plan pregnancy at a later stage in life or who may undergo medical treatments that could affect reproductive health. Egg and ovarian cortex freezing allows women to safeguard their future fertility through advanced cryopreservation techniques. In this process, mature eggs or a small portion of ovarian tissue is carefully collected and frozen in specialized laboratories, allowing them to be stored for future use when the patient is ready to conceive. Through CureMeAbroad, patients can access internationally accredited fertility clinics that offer modern fertility preservation technologies and experienced reproductive specialists. Each treatment plan is customized based on the patient’s age, medical condition, and long-term family planning goals. The clinics follow strict medical protocols to ensure the safe collection, freezing, and storage of reproductive tissue. With expert medical guidance and advanced fertility preservation methods, patients receive reliable support while planning for future parenthood with confidence.

Egg Donation
Egg donation abroad is a fertility treatment option designed for women who are unable to conceive using their own eggs due to medical conditions, genetic concerns, or age-related fertility decline. In this process, eggs from a carefully screened healthy donor are fertilized with sperm in a specialized laboratory using advanced reproductive techniques. The resulting embryo is then transferred into the recipient’s uterus with the goal of achieving a successful pregnancy. Through CureMeAbroad, patients can connect with internationally accredited fertility clinics that offer well-regulated egg donor programs, advanced embryology laboratories, and experienced fertility specialists. Donors are carefully evaluated through medical and genetic screening to ensure safety and compatibility. Each patient receives a personalized treatment plan tailored to their unique fertility needs. Choosing egg donation abroad allows patients to access advanced fertility technologies, high-quality medical care, and structured donor programs that support individuals and couples on their journey toward parenthood.

Embryo Donation
Embryo Donation is a critical component of modern medicine, offering patients access to minimally invasive, highly effective treatments that can significantly improve outcomes across various health domains.

Artifical Insemination (Donor)
Artificial insemination with donor sperm, commonly known as donor IUI, is a straightforward, minimally invasive fertility treatment that places carefully screened donor sperm directly into the uterus during ovulation, maximising the chance of natural conception. It is a popular first-line option for single women, same-sex female couples, and heterosexual couples affected by male factor infertility. Travelling abroad for donor IUI gives you access to experienced fertility specialists, accredited donor sperm programmes, and comprehensive care at considerably lower costs than at home. On CureMeAbroad, compare verified providers, explore top medical tourism destinations, and review transparent pricing honestly. No commissions, no pressure, just confident decision-making.

Egg Freezing (Oocyte Cryopreservation)
Egg freezing abroad provides women the opportunity to conserve their ability to have children in the future and choose when they would like to conceive as opposed to having to consider conception based upon age. Treatment abroad for egg freezing consists of stimulation of the ovaries to release multiple eggs. These eggs are retrieved via a minor surgical technique known as egg retrieval (typically performed under sedation) and subsequently frozen for potential use in the future. A number of women opt to freeze their eggs due to the fact they wish to delay childbearing for either personal, professional or medical reasons. Additionally, egg freezing may provide an option for individuals that will be receiving treatments that could potentially impact reproductive capacity. The eggs collected during the egg freezing process can remain viable for a long period of time due to the advancement of laboratory technology used to preserve eggs. CureMeAbroad helps connect prospective parents with top international fertility clinics utilizing cutting-edge reproductive technologies and experienced professionals. CureMeAbroad's staff assist with arranging your fertility treatment, selecting a clinic, coordinating your travel arrangements, thereby allowing you to focus on achieving your fertility goals with confidence and peace of mind.

In Vitro Maturation (IVM)
As a specialized medical solution, In Vitro Maturation (IVM) combines technological innovation, clinical expertise, and patient-centered strategies to optimize recovery, minimize complications, and ensure better overall healthcare experiences.
Embryo Oocyte and Sperm Cryopreservation
Embryo Oocyte and Sperm Cryopreservation represents an innovative procedure aimed at enhancing diagnostic accuracy, delivering targeted therapy, or facilitating surgical precision depending on the patient's unique needs.

Tubal Ligation Reversal
Through the application of Tubal Ligation Reversal, healthcare providers are able to address complex medical conditions with precision, utilizing the latest advancements in technology and evidence-based practices.

Laparoscopic Hysteroscopy and Sonohysterography
Laparoscopic Hysteroscopy and Sonohysterography represents an innovative procedure aimed at enhancing diagnostic accuracy, delivering targeted therapy, or facilitating surgical precision depending on the patient's unique needs.

Assisted Laser Hatching
Assisted laser hatching is an advanced fertility technique used alongside IVF, where a precise laser is used to create a small opening in the outer shell of an embryo, helping it implant more successfully into the uterine lining. It is particularly recommended for patients with previously failed IVF cycles, older embryos, or a thickened zona pellucida. Travelling abroad for assisted laser hatching gives you access to leading fertility specialists and state-of-the-art reproductive clinics at considerably lower costs than at home. On CureMeAbroad, compare verified providers, explore top destinations, and review transparent pricing honestly. No commissions, no pressure, just confident decision-making.

Semen Freezing
Semen freezing is a fertility preservation technique that stores semen samples at ultra-low temperatures, maintaining their viability for use in future IVF, IUI, or other assisted reproduction treatments. It is recommended for men prior to medical procedures that may affect fertility, those with declining sperm counts, or anyone wishing to plan for parenthood at a later stage. Travelling abroad for semen freezing connects you with specialist andrology laboratories and experienced fertility teams at considerably lower costs than at home. On CureMeAbroad, compare verified providers, explore top medical tourism destinations, and review transparent pricing honestly. No commissions, no sales pressure, just confident decision-making.

Reproductive Surgery
Through the application of Reproductive Surgery, healthcare providers are able to address complex medical conditions with precision, utilizing the latest advancements in technology and evidence-based practices.

Pre-implantation Genetic Screening (PGS)
As a specialized medical solution, Pre-implantation Genetic Screening (PGS) combines technological innovation, clinical expertise, and patient-centered strategies to optimize recovery, minimize complications, and ensure better overall healthcare experiences.

Ovarian Rejuvenation
Ovarian Rejuvenation is a critical component of modern medicine, offering patients access to minimally invasive, highly effective treatments that can significantly improve outcomes across various health domains.
Loading...
World’s No. 1 Medical Discovery Platform
CureMeAbroad
Is Absolutely Free
Access exclusive hospital rates with zero service fees.
Get an expert by your side for the entire journey—at no cost to you.
World’s No. 1 Medical Discovery Platform
Get Free Consultantion
Schedule Now
Access exclusive hospital rates with zero service fees.
Get an expert by your side for the entire journey—at no cost to you.
We offer a wide range of treatments including surgery, chemotherapy, physiotherapy, and advanced diagnostic procedures.
Yes, treatments are personalized based on the patient's medical history, diagnosis, and specific health needs.
Absolutely. Our specialists are available for second opinions to ensure you have confidence in your treatment plan.
Treatment durations vary depending on the type and complexity, ranging from a few minutes (e.g., diagnostic tests) to several weeks or months (e.g., cancer treatment).
Yes, we offer specialized treatment packages for international patients including airport pickup, accommodation, and dedicated care coordinators.
Yes, comprehensive follow-up care is included to monitor recovery and ensure long-term health outcomes.
Many of our treatments are covered by major insurance providers. Please check with your insurer for specific coverage details.
What types of treatments are available?
Are treatments customized for each patient?
Do you provide second opinion consultations for treatments?
How long do treatments usually take?
Are treatment packages available for international patients?
Is follow-up care provided after treatment?
Are treatments covered by insurance?
What types of treatments are available?

We offer a wide range of treatments including surgery, chemotherapy, physiotherapy, and advanced diagnostic procedures.
Help Me Plan
My
Treatment Abroad
Access exclusive hospital rates with zero service fees. Get an expert by your side for the entire journey—at no cost to you.


Book Your Free Medical Consultation
Get expert advice—free and easy. Start your healthcare journey today.
